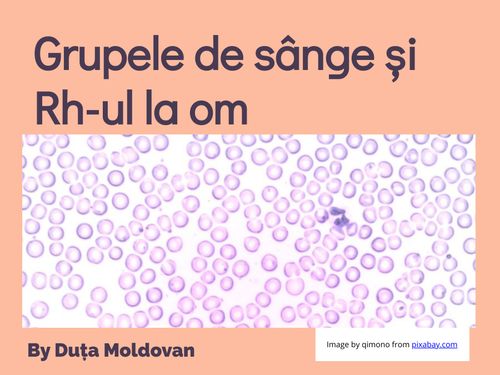
Grupele de sânge și Rh-ul la om

Descriere:
Resursa se adresează elevilor de clasa a VI-a și are scopul de a facilita înțelegerea compatibilității grupelor de sânge, a RH-ului și importanța acestora în transfuzii.
Suita de activități include informare, despre antigene și anticorpi, organizată sub formă de text, tabel și solicită interpretarea unor scheme intuitive și a videoclipului cu animații despre regulile de transfuzie.
Poate fi utilizată de către profesor în dirijarea învățării. Resursa are caracter ludic prin quiz-ul inclus, care poate fi valorificat în consolidare sau evaluare.
Tipul resursei: Suită de activități
Limba resursei: Română
Nivelul: Clasa a VI-a
Disciplina: Biologie
Competență generală: 3. Rezolvarea unor situații problemă din lumea vie pe baza gândirii logice și a creativității
Competența specifică vizată prioritar: 3.1.. Interpretarea diverselor modele ale unor sisteme biologice
Legătura web către resursă: https://read.bookcreator.com/rNRryPbnupenTPpqqNEMo4q8bYz1/-u_8KzmpRj-3rRnCl_2MOw
Accesări: 710
Propunător: Duța Moldovan - Colegiul Național Andrei Mureșanu, Bistrița (Bistriţa-Năsăud)
Data validării: 22 februarie 2023
![]()
Licență: CC BY-NC-SA 4.0, Atribuire-necomercial-distribuire în condiţii identice 4.0 internațional
Conținutul acestei platforme poate fi utilizat liber cu condiția menționării sursei și, unde e posibil, a autorului. Modificarea este permisă, iar operele derivate trebuie, la rândul lor, să poată fi utilizate liber și modificate fără restricții.